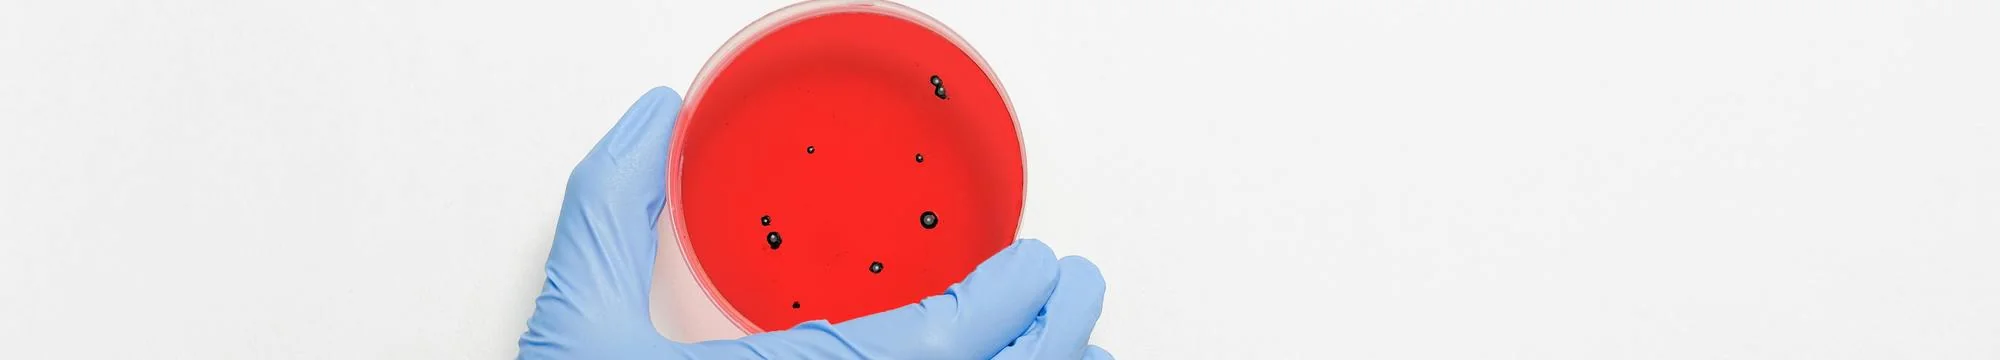
Frontiers of Scientific Discovery: Protein Evolution, Spatial Transcriptomics, and Antibody Research

Back to Archive

News and Views
English
Frontiers of Scientific Discovery: Protein Evolution, Spatial Transcriptomics, and Antibody Research
Neher Aseem Parimoo, Cinthya Souza Simas, Sara Tóth Martínez, Gerhard Steinmann, Roland Mertelsmann
Journal of Science, Humanities and Arts (JOSHA), University of Freiburg, International Academy of Sciences, Humanities, and Arts (IASHA e.V.)
Views
823
Downloads
1,426
Community Rating
Abstract
To enhance communication, JOSHA presents a curated selection of articles chosen by its editors. This edition highlights innovative research, including EVOLVEpro, a protein engineering method that integrates protein language models and active learning to optimize enzymes, antibodies, and gene-editing tools; bacterial-MERFISH, a technique for high-resolution bacterial transcriptomics that provides new insights into bacterial behavior and interactions; a reflective piece on the impact of casual academic interactions in overcoming professional hierarchies; and a study on the differential proliferation of plasma cells in antibody affinity maturation, emphasizing the role of IL-21 in promoting high-affinity antibody responses. These studies contribute significantly to advancements in biotechnology, microbiology, and immunology.
Rate this research
Help the community discover quality papers.
Thank you for your rating!
Discussion
Thank you for your comment!
We will review it carefully. Please understand that it may take a little longer before we can publish it.
There are no comments yet. Be the first to share your thoughts!
Article Information
Title
Frontiers of Scientific Discovery: Protein Evolution, Spatial Transcriptomics, and Antibody Research
Type
Article
Published in
Journal
19. May 2025
DOI Identifier
10.17160/josha.12.3.1044
Copied to clipboard!
Language
English
Journal
Vol 12 Issue 3
Categories
News and Views
Authors
Neher Aseem Parimoo1, Cinthya Souza Simas1, Sara Tóth Martínez2,3, Gerhard Steinmann4, Roland Mertelsmann2
Affiliations
1
Journal of Science, Humanities and Arts (JOSHA)
2
Journal of Science, Humanities and Arts (JOSHA)
3
University of Freiburg
4
International Academy of Sciences, Humanities, and Arts (IASHA e.V.)
This article is open access and distributed under the terms of the Creative Commons Attribution 4.0 International License.
Cite this work
Neher Aseem Parimoo et al. (2025). "Frontiers of Scientific Discovery: Protein Evolution, Spatial Transcriptomics, and Antibody Research". JOSHA Journal. DOI: 10.17160/josha.12.3.1044.
